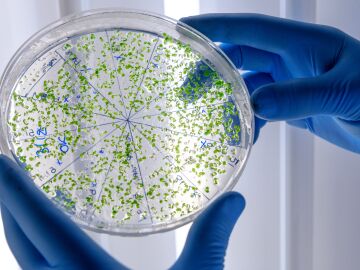

Tres parapléjicos vuelven a caminar gracias a una terapia con estimulación eléctrica

Investigadores españoles desarrollan una nanoterapia que evita el rechazo de los órganos trasplantados

Disponible un nuevo fármaco que retrasa el avance de un tipo de cáncer de pulmón

Desarrollan una retina artificial para implantar en personas ciegas y que probarán inicialmente en cerdos

Implantan a un niño de diez años una mandíbula hecha con una impresora 3D en China

¿Será la solución definitiva a la alopecia? La clonación capilar será efectiva en diez años







